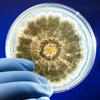

Adidas je prostovoljno odpoklical in iz prodaje umaknil svoje otroške kopalke Infinitex® 3-Stripes, ki so bile izdelane v Tuniziji. "Družba močno priporoča, da otroci do vključno 14. leta starosti ne uporabljajo navedenih kopalk oziroma z njihovo uporabo takoj prenehajo," so zapisali v sporočilu za javnost.
Neodvisna preiskava je pokazala, da uporaba kopalk, opremljenih s tremi trakovi, predstavlja morebitno varnostno tveganje za otroke, Trakovi se lahko zataknejo za predmete ali druge osebe v vodi oziroma na kopnem in se zapletejo, kar lahko pripelje do poškodb. Iz podjetja sicer sporočajo, da obvestil o morebitnih poškodbah še niso prejeli.
Omenjene kopalke so umaknili iz prodajaln in ustavili prodajo na njihovi spletni trgovini. Podjetje je o odpoklicu obvestilo vse svoje pooblaščene trgovce in jih pozvalo, naj omenjene kopalke umaknejo iz prodaje in zalog.
Kopalke, ki jih adidas umika iz prodaje, so iz linije Infinitex® 3-Stripes in opremljene s tremi črtami. V sklopu kolekcij 2017 in 2018 so bile naprodaj v spletni trgoviniadidas.com, v adidasovih trgovinah in pri pooblaščenih trgovcih po vsem svetu. Pomagate si lahko tudi s fotografijami na spletni strani adidas.com, da bi ugotovili, ali obvestilo o umiku izdelkov velja tudi za njihove kopalke.
Kako jih prepoznati?
Kopalke v različnih barvnih kombinacijah, tri črte so natisnjene na obeh straneh. Na etiketah omenjenih izdelkov se nahaja napis "Izdelano v Tuniziji" (Made in Tunisia). Prav tako je na notranji strani izdelkov natisnjena ena od naslednjih serijskih številk (velja tako za otroške kot tudi za odrasle velikosti): BP9506, BP9508, BP9509, BQ3161, BP9529, BP9530, BP9532, CF9089, BP9514, BP9516, BP9533, BP9534, BP9535, BP9510, BP9512, BP9513, BP9520, BP9521, BP9525, BP9522, BP9524, BP9526, BS0319, BS0325, BS0404, BP9513, BS0358, BP9520, BP5874, BR5956, BP9522, CX5044, CX5045, CV3652, CV3653, CV3664, BS0352, CV3650, CV3651, BS0397, BP5874, CW4813, CW4814, BR5956, BP5880, CW4815, CW4816, BR5950, BQ3161, DH2404, DH2405, DL8723, BS0397, BS0352, DH2401, CW4813, CW4814, DH2198, DH2190, CW4815, CW4816, DH2176, DH2189, CY1720, CY1721, CX5044, CX5045.
Kopalke lahko vrnete v katero koli adidasovo trgovino ali pooblaščenim prodajalcem, pri katerih ste izdelke kupili. Kupnino vam bodo povrnili.

Sliko pa bohnedi pripopat ......amaterji